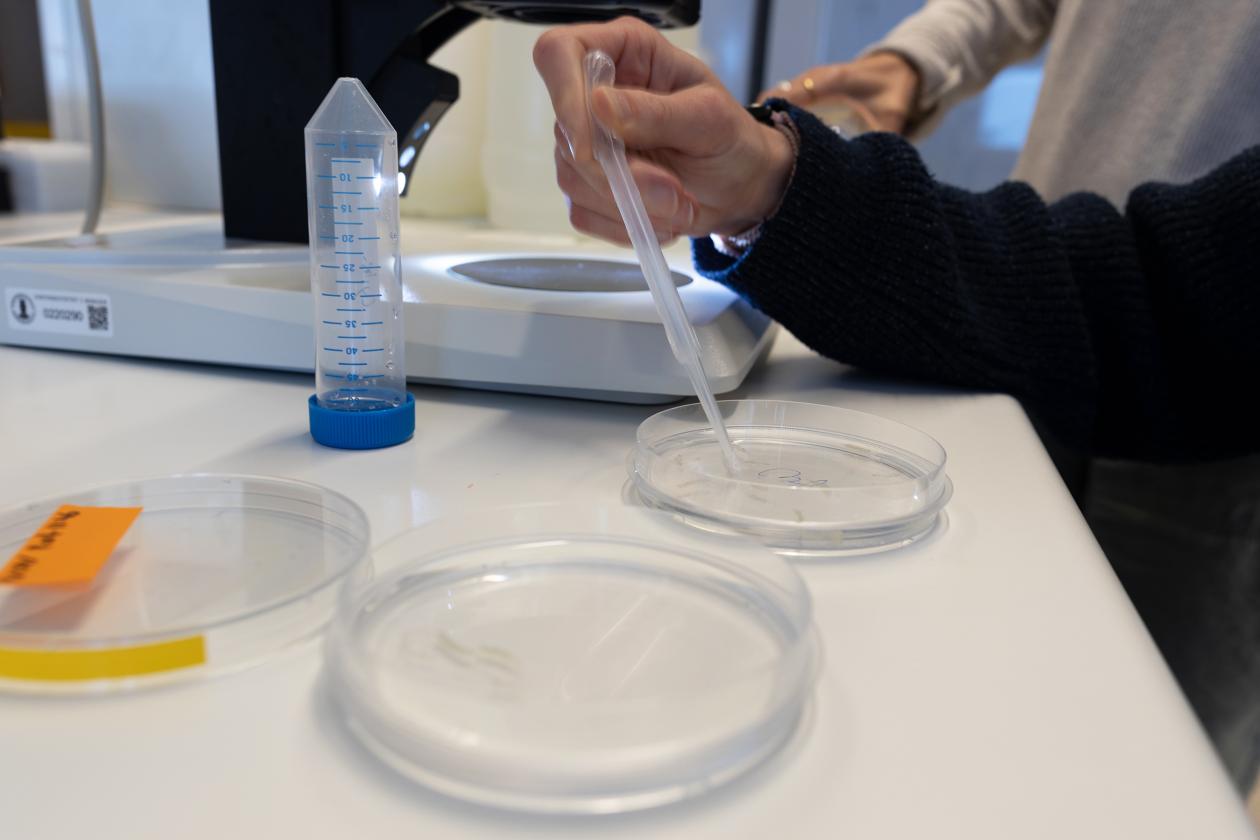

Guest researchers from KAUST visit the Michael Sars Centre to learn new techniques
PhD candidates Mascha Dix and Jessica Menzies visited the Centre from Saudi Arabia to develop their microinjection skills in the Steinmetz group.
Main content
The Michael Sars Centre recently welcomed PhD candidates Mascha Dix and Jessica Menzies from the King Abdullah University of Science and Technology (KAUST) in Saudi Arabia. They visited the laboratory of Dr. Patrick Steinmetz to receive training in microinjection techniques for sea anemone eggs. Jessica and Mascha plan to apply these new skills to their projects on symbiosis in corals in the Coral Symbiomics Lab at KAUST.
Jessica, originally from the UK, has contributed to establishing a coral facility and technical tools at KAUST as part of her PhD. She planned the duo’s visit to Bergen to kick-start the next step of their projects. “It was more about seeing how people handle different problems with the species that they're working on. And it's been very useful so far”, she said. Mascha, who comes from Germany, shared similar sentiments. “We’re trying to set things up. So you don't really know how it's even supposed to work and even try to set it up”, she explained. “You're like, I'm not sure if I'm doing this right? So it's really cool to just sort of see a place where it's so standardized and smooth.”

Mascha checks on the eggs before injection.
Inés Fournon Berodia, PhD candidate in the Steinmetz group, tutored the visiting students. “As I now enter my final year, sharing the knowledge that I learnt at the beginning of my PhD journey feels very good and almost full-circle”, she said. “These last weeks of teaching not only enriched the students who were learning but I also feel like I learn a lot every time I have an opportunity to teach or share my experiences with fellow scientists, definitely a win-win situation.”
Mascha and Jessica also used their time at the Centre to practice microinjections on the larvacean Oikopleura dioica, with the help of postdoctoral researcher Xiaofei Ma from the Chourrout group. As they prepare to return to Saudi Arabia, their take-away goes beyond technical skills. “We’re planning to take some Nematostella back to KAUST. I think it’s just really nice to be able to compare between different cnidarians”, Mascha shared. Jessica concluded: “We are definitely on the right track, we have loads of ideas.”